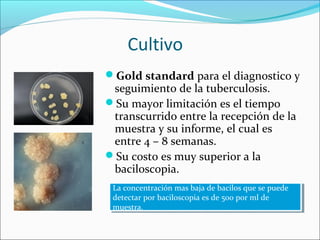
Cultivo
Gold standard para el diagnostico y
 seguimiento de la tuberculosis.
Su mayor limitación es el tiempo
 transcurrido entre la recepción de la
 muestra y su informe, el cual es
 entre 4 – 8 semanas.
Su costo es muy superior a la
 baciloscopia.
 La concentración mas baja de bacilos que se puede
  La concentración mas baja de bacilos que se puede
 detectar por baciloscopia es de 500 por ml de
  detectar por baciloscopia es de 500 por ml de
 muestra.
  muestra.

Este documento describe los diferentes métodos de diagnóstico de la tuberculosis pulmonar, incluyendo pruebas microbiológicas (baciloscopia, cultivo), radiología e histopatología. Explica que la baciloscopia es la prueba de elección debido a su sencillez, pero el cultivo es el estándar de oro aunque más lento. También detalla la importancia de la recolección y procesamiento adecuado de las muestras respiratorias para un diagnóstico efectivo.